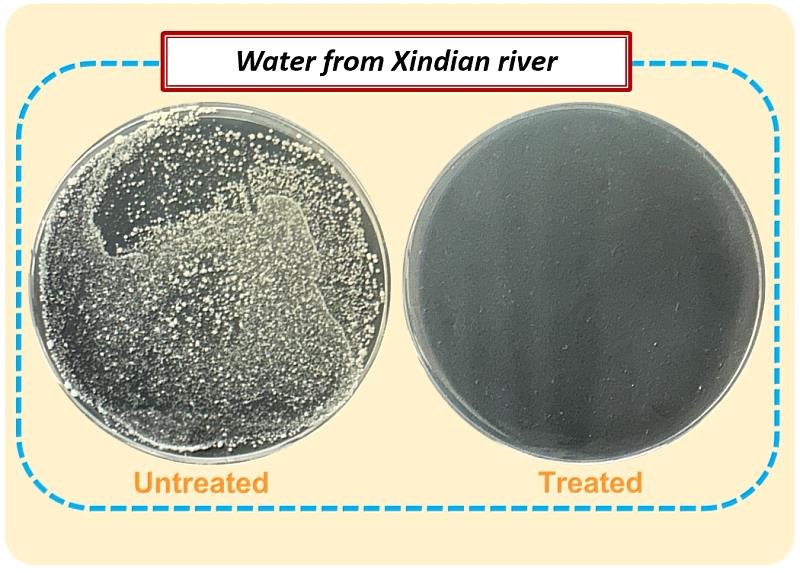
研究團隊在奈米管表面塗覆碲化鉍（Bi₂Te₃），並以新店溪溪水進行實驗，透過熱催化效應達到約97%的大腸桿菌滅菌效果。

臺科大攜手臺大開發自供電水質監測系統 偵測重金屬、殺菌一次搞定
(中央社訊息服務20260407 10:24:44)乾淨且安全的水資源是全球永續發展的重要基礎,但隨著工業化與都市化持續擴張,水污染問題日益受到關注。國立臺灣科技大學材料系朱瑾教授研究團隊,攜手國立臺灣大學醫工系林宗宏教授團隊開發出「液固摩擦奈米感測器」,可在不依賴外部電源的情況下,同步完成重金屬、細菌偵測與水質淨化等工作,研究成果已刊登於國際高影響力期刊《Advanced Functional Materials》(Impact factor: 19.0),為智慧化水質監測提供新的技術方向。

「液固摩擦奈米感測器」整合兩校材料工程與生醫感測兩大領域的研究優勢,林宗宏教授團隊長期投入智慧生醫材料與自驅動化學感測器的開發,在遠端智慧監控平台與生醫應用方面具備成熟的技術;朱瑾教授團隊則專注金屬奈米管陣列結構與表面處理能力,研發高功能奈米材料,透過兩校團隊的技術整合,成功打造出兼具「污染物偵測」與「水質處理」能力的自供電水質監測系統。
在材料設計方面,臺科大團隊以鎳、鎢與鎳(Ni-W-Ni)組成的金屬奈米管為核心,當水滴在奈米管表面滾動時,水滴與奈米管結構之間的接觸與分離會產生摩擦電,系統將這些電蒐集轉換為電能,進而驅動感測與殺菌。不同於現有多數水質監測系統需要持續供電或外接設備,此技術透過水滴運動即可產生電力,不僅降低能源消耗,也為水質監測帶來更節能、低碳且兼具環保永續的創新方案。

此外,研究團隊開發的感測器可結合不同的檢測晶片進行鉻、鉛及汞等重金屬離子的檢測,同時也能辨識常見的病菌,如大腸桿菌與金黃色葡萄球菌。在性能表現上,感測器於離子檢測時的反應時間僅約20毫秒,而對大腸桿菌的靈敏度可達163 mV/decade,相較於傳統感測技術,展現更快速且靈敏的監測能力。
除了偵測污染物外,團隊也在奈米管表面塗覆碲化鉍(Bi₂Te₃),它能在溫差約10°C的條件下產生過氧化氫(H₂O₂),達到約97%的大腸桿菌滅菌率、95%的金黃葡萄球菌滅菌率,以及約95%的六價鉻還原效率。研究團隊指出,一個約1平方公分的檢測模組即可處理約10毫升的水量,還能透過調整奈米管表面潤濕性、直徑、長度與排列密度等影響感測靈敏度與產電效率,使整體系統能依不同需求進行客製化設計。
為了讓技術更貼近實際應用情境,研究團隊將感測、殺菌與監測平台等功能整合成「無線感測瓶」裝置,使用者只需將水樣滴入裝置中,系統便可立即完成污染物感測,並進行初步淨化處理,相關數據還能透過無線傳輸到物聯網(IoT)平台,建立智慧化的水質監測網絡,適合應用在分散式水質監測與即時處理場景,例如河川污染、偏鄉地區水質監測、災害現場水源檢查以及工業排放廢水的即時抽查等,這種無需外接電源、可攜式系統能在第一時間提供快速檢測與初步處理,形成重要的前端防護。

研究團隊學生Helmi Son Haji也指出,真實環境中的水質通常含有多種複雜污染物,可能造成感測層表面污染或功能衰退,因此未來將強化防汙設計、表面保護技術及模組化更換機制,以提升系統的長期穩定性與耐用度,未來還可透過更換感測晶片,將檢測範圍拓展至農藥殘留、其他化學污染物甚至新興污染物的偵測。
藉由臺科大與臺大研究團隊的跨校合作,激盪出具備自供電、模組化製程、簡便可攜、感測與殺菌整合的平台,為水資源監測與污染治理提供新的技術思路,未來隨著技術持續優化,相關成果也有望在環境監測與永續水資源管理領域發揮更大影響力。






